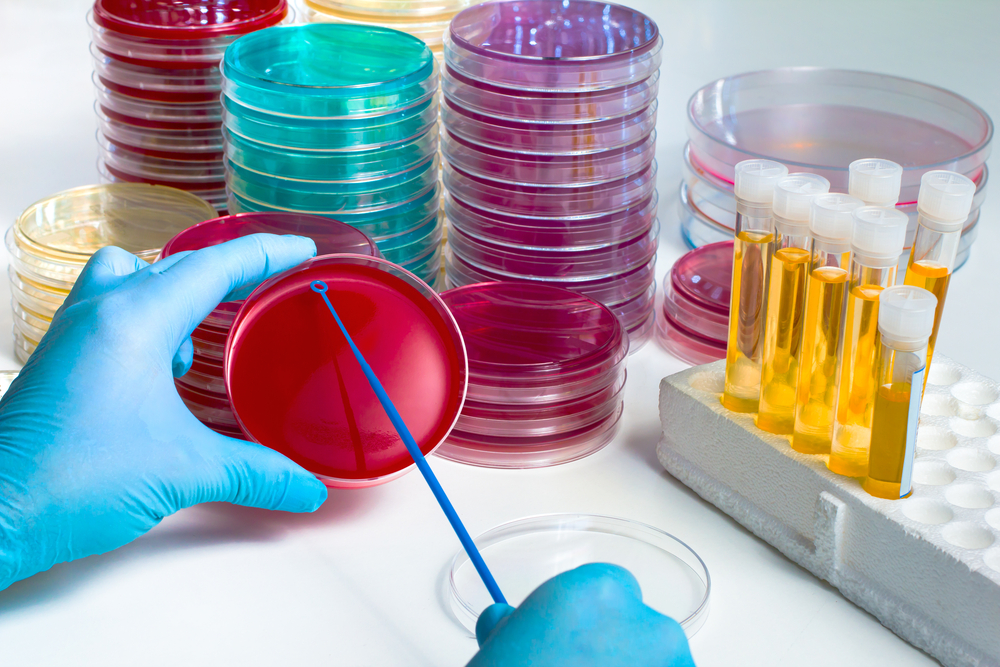

Expert chronicling Hamas’ gender-based crimes wins Israel Prize
Project based on images, videos, testimonials and press sources aims to aid victims and families learn more about what happened on October 7.

Project based on images, videos, testimonials and press sources aims to aid victims and families learn more about what happened on October 7.

‘Israel has become a major source of innovation in the understanding and treatment of cancer,’ says director of Israel Cancer Research Fund.
As part of Cancer Research Month, we take a look at some of the best Israeli research in the field of cancer and the scientists committed to saving lives.